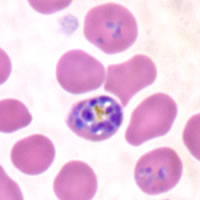
P. falciparum schizonts - thin smear

|
|
[Last Modified: ] |
|
|
|
| [Plasmodium
falciparum] [Plasmodium malariae] [Plasmodium ovale] [Plasmodium vivax] |
Plasmodium falciparum: Schizonts
 |
Figs. 19-25: Increasingly
mature schizonts; Fig. 26: Ruptured schizont.
Illustrations from:
Coatney GR, Collins WE, Warren M, Contacos PG. The Primate Malarias. Bethesda:
U.S. Department of Health, Education and Welfare; 1971.
Smears from patients:
Schizonts are seldom seen in peripheral blood. Mature schizonts have 8 to 24 small merozoites; dark pigment, clumped in one mass.
|
 |
| A | B |
A:
Immature schizont in thin blood smears.
B: Mature schizont.
 |
 |
| C | D |
C, D: Ruptured schizonts in a thin blood smear.
|
|||